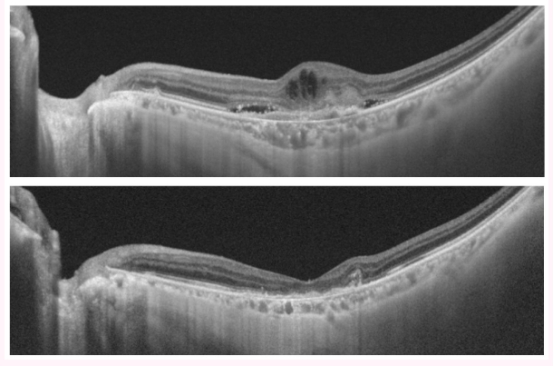

全球服务热线:400-086-8008
首页 > 权威医院 > 日本医院 > 东京女子医科大学附属医院
医院概况
东京女子医科大学医院是日本认定的特定职能医院(相当于国内的三甲医院),是日本较大的大学医院,拥有世界先进的医疗服务,致力于尖端的癌症治疗,可以进行进行更高质量的临床研究和临床试验。东京女子医科大学医院拥有将MRI设备引入手术室并在手术过程中捕获MRI图像的高级智能手术室、新生儿的新医疗服务(如一氧化氮(NO)吸入装置和低温疗法)、血运重建和连续负压吸引疗法、内窥镜手术、达芬奇机器人手术、先进的放射治疗技术、伽马刀技术、人工血管支架植入术(EVER)等世界先进的医疗技术。在检查方面,该院拥有超声支气管镜(EBUS)、唾液腺内窥镜检查(SIALENDOSCOPY)、先进的医学PET和PET / CT。
医院简介
东京女子医科大学医院开设于1908 年 (明治 41 年),目前已有110多年的历史,是日本一流医科大学—东京女子医学校的附属医院。东京女子医院一直坚持从患者的视点来为患者提供安全、安心的医疗实践和高度的先进的医疗服务的基本原则,秉承创建者提出的"至诚与爱"理念提供患者安全安心的医疗。作为特定机能医院,竭诚推广先进医疗及高超医疗技术,并为附近地区的医疗做出了杰出贡献。该院还积极培养有担当的医护人员,制定充分的教学计划及富实践性的研修计划。

舒适、宽敞的诊疗就医环境

医院内部环境
医院优势
乳腺・内分泌外科
乳腺诊疗科每年有约300人的乳腺癌手术的经验,致力于使用超声波和乳管内视镜诊断早期乳癌,与其他科室相关联采用化疗和放射线结合积极治疗,外科治疗中以前哨淋巴结活检为依据可以免去腋下淋巴结廓清术等先进医疗技术,重视外观美容考虑保乳手术或重建手术达到治疗乳腺癌的目的。
脑神经外科
东京女子医科大学附属医院有着先进的医疗技术,可以为脑神经疾病,尤其是难治性脑神经科病变提供更优质的服务,如可采用术中MRI、清醒状态下实行开颅手术保护语言中枢不受损害;在内视镜下治疗脑积水并切除肿瘤,;经鼻镜切除下垂体肿瘤;脑肿瘤血管病变等的伽玛刀治疗;恶性脑肿瘤的PRS术中局部放射线治疗;动脉瘤,动静脉畸形的血管内治疗;颈内动脉内膜剥离术;血管吻合搭桥术,未破裂的动脉瘤的外科治疗及探索遗传基因的因果关系,以及难治癫痫的外科治疗等。
风湿免疫科
该科室专门研究风湿病,例如类风湿关节炎和痛风等,希望为患者提供更多的医疗服务。该科室的全体医护人员以“更高质量的医疗服务”,“更先进的研究”和“更有吸引力的教育”为目标,为患者提供更权威的治疗方法以及新的药物疗法,如生物制剂和小分子靶向治疗剂。
眼科
为患者提供适合本人的视功能门诊诊疗以外还有黄斑门诊,视网膜、玻璃体角膜、干眼症泪腺疾病青光眼葡萄膜炎神经眼科斜视弱势未成熟儿眼科、色盲、低视力等各科的专门领域,采用先进诊断仪器和治疗装置,及特殊的治疗手段。从而积累了丰富的临床业绩。
特别是造成失明主要原因的疾病退行性黄斑病变等的治疗,有独特的治疗手段,开设了「黄斑疾病综合医疗门诊」具有专业性强,技术高的综合诊疗方法。同时对视网膜剥离和黄斑疾患等视网膜玻璃体疾患为开端,对白内障也同样,进行积极的使视力恢复为目的的治疗研究,采用先进的手术器诫及高端的手术技术来完成以上疾患的治疗。

使用抗血管内皮生长因子(VEGF)剂治疗湿性老年性黄斑变性
在治疗前通过光学相干断层扫描(OCT)观察到的视网膜水肿(上图)在治疗后消失(下图)
心脏血管外科
心脏血管外科设立于1955 年具有悠久的历史,是本院较大的诊疗科,病例数到 2016 年为止,心脏大血管手术数超过了 37,000 例。该科的特色之一是可以治疗日本所有可以进行的所有心血管外科治疗,诊治病例有先天性心脏病,冠心病,心脏瓣膜病,心律不齐,重症心衰等。
在成人心血管外科手术中,该科室始终考虑“不给患者增加身体负担的微创治疗”,并且约有97%或更多的冠状动脉搭桥手术是通过不使用体外循环手术的非体外循环进行的。
该科室还旨在使瓣膜疾病尽可能微创。对于二尖瓣血管成形术,通过左切口小切口开胸手术进行MICS手术,对于主动脉瓣狭窄,则进行经导管主动脉瓣植入术(TAVI)。
此外,在主动脉疾病方面,该科室配备了齐全的混合手术室,并积极开展支架移植治疗,以应对多种疾病。
另外,作为心脏移植实施机构,东京女子医科大学附属医院积极开展心脏移植手术。对于患有严重心力衰竭和心脏移植适应症的患者,还积极实施可植入辅助人工心脏。
在心内科・小儿心脏科・麻醉科・临床工学・护理部各部密切联合提携创立了日本的高手术例数和高手术业绩。特别是需要高度医疗技术的复杂的心脏畸形的手术业绩获得世界很高的评价。
该院是日本有限的开展经动脉导管行主动脉瓣置换术(TAVI)的医院之一。另外,该院拥有世界先进的人工血管支架植入术(EVER),可以在胸骨部分切开,胸骨旁切口、右小开胸下行主动脉瓣置换术(MICS AVR)。

TAVI手术现场
消化器内视镜科
该院在消化科内视镜检查,以及消化系统癌症的治疗方面,在日本国内具有丰富的经验和较高的治疗成绩。
消化科内视镜检查
同时,该院开展了肝内胆管癌采用树状细胞癌疫苗疗法的先端治疗研究,与化疗并用达到更好的治疗效果。
临床信息
日本东京女子医科大学附属医院现有约40个诊疗科室和癌症中心以及15个诊疗支援部门,病床数1194张,医护人员2821人。年间入院患者数958人,年间外来患者数3,596人。
该院是具有国家认定的职能机构: 急救指定医院、污染医疗机构、临床研修指定医院、临床实习指定医院、灾害应急医院、艾滋病治疗定点医院、神经系统难病医疗定点医院、临床治验医疗机构、肝脏专门医疗机构、移植认定设施(心脏小儿心脏肾脏胰脏肝脏骨髓末梢血干细胞)、东京都脑卒中急性期医疗机构、综合围产期母子医疗中心、东京DMAT指定医院、东京难病诊疗提携据点医院、肝癌・重度肝硬化治疗研究促进事业指定医疗机构。
东京女子医科大学附属医院临床支持中心于2019年4月改为东京女子医科大学临床研究促进中心,该中心是监督临床研究活动并促进与临床研究有关的教育的组织,由医院内的临床研究部门和临床试验部门组成。在该中心,相关人员将促进考虑患者人权的高质量临床研究,同时支持新药的开发,旨在为患者提供新的医疗服务。

高级智能手术室的手术现场
主要科室
就诊时间

休息日:日本国法定节假日,12月29~1月3日
医院地址
简称 :东京女子医科大学医院
地址 :〒162 -8666 東京都 新宿区 河田町 8-1
信息来源 东京女子医科大学医院官方网址http://www.twmu.ac.jp/info-twmu/
编译:厚朴方舟
免责声明:本公司力求为用户提供准确、客观的信息资料与数据,公司所提供的信息均来源于网络上公开发表的文献或文章,仅供用户参考使用,用户据此作出的选择和判断,公司不承担任何经济与法律责任。
全球咨询服务热线
400-086-8008
English | 微信端

互联网药品信息服务资格证书编号:(京)·非经营性·2015·0179
厚朴方舟健康管理(北京)有限公司 版权所有 www.hopenoah.com
京ICP备15061794号
京公网安备 11010502027115号